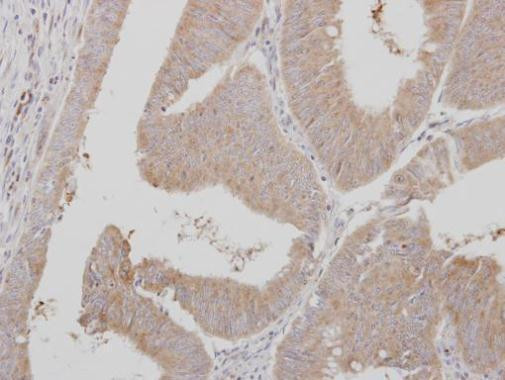
ADAMTSL1 Antibody in Immunohistochemistry (Paraffin) (IHC (P))

Search
Invitrogen
ADAMTSL1 Polyclonal Antibody
{{$productOrderCtrl.translations['antibody.pdp.commerceCard.promotion.promotions']}}
{{$productOrderCtrl.translations['antibody.pdp.commerceCard.promotion.viewpromo']}}
{{$productOrderCtrl.translations['antibody.pdp.commerceCard.promotion.promocode']}}: {{promo.promoCode}} {{promo.promoTitle}} {{promo.promoDescription}}. {{$productOrderCtrl.translations['antibody.pdp.commerceCard.promotion.learnmore']}}
产品信息
PA5-31013
宿主/亚型
分类
类型
抗原
偶联物
形式
浓度
规格
保存条件
运输条件
RRID
产品详细信息
Recommended positive controls: HepG2.
Predicted reactivity: Mouse (98%).
Store product as a concentrated solution. Centrifuge briefly prior to opening the vial.
靶标信息
Punctin (ADAMTSL-1) is a secreted molecule, expressed in adult skeletal muscle, resembling members of the ADAMTS family of proteases, containing four thrombospondin type I repeats. Human punctin cleaves aggrecan and is thereby classified as an aggrecanase. Like the ADAMTS proteases, each domain in punctin has an even number of cysteine residues suggesting that each domain may have internal disulfide bonds and that punctin consists of a series of independently folded and disulfide-bonded domains.
⚠WARNING: This product can expose you to chemicals including mercury, which is known to the State of California to cause birth defects or other reproductive harm. For more information go to www.P65Warnings.ca.gov.
仅用于科研。不用于诊断过程。未经明确授权不得转售。